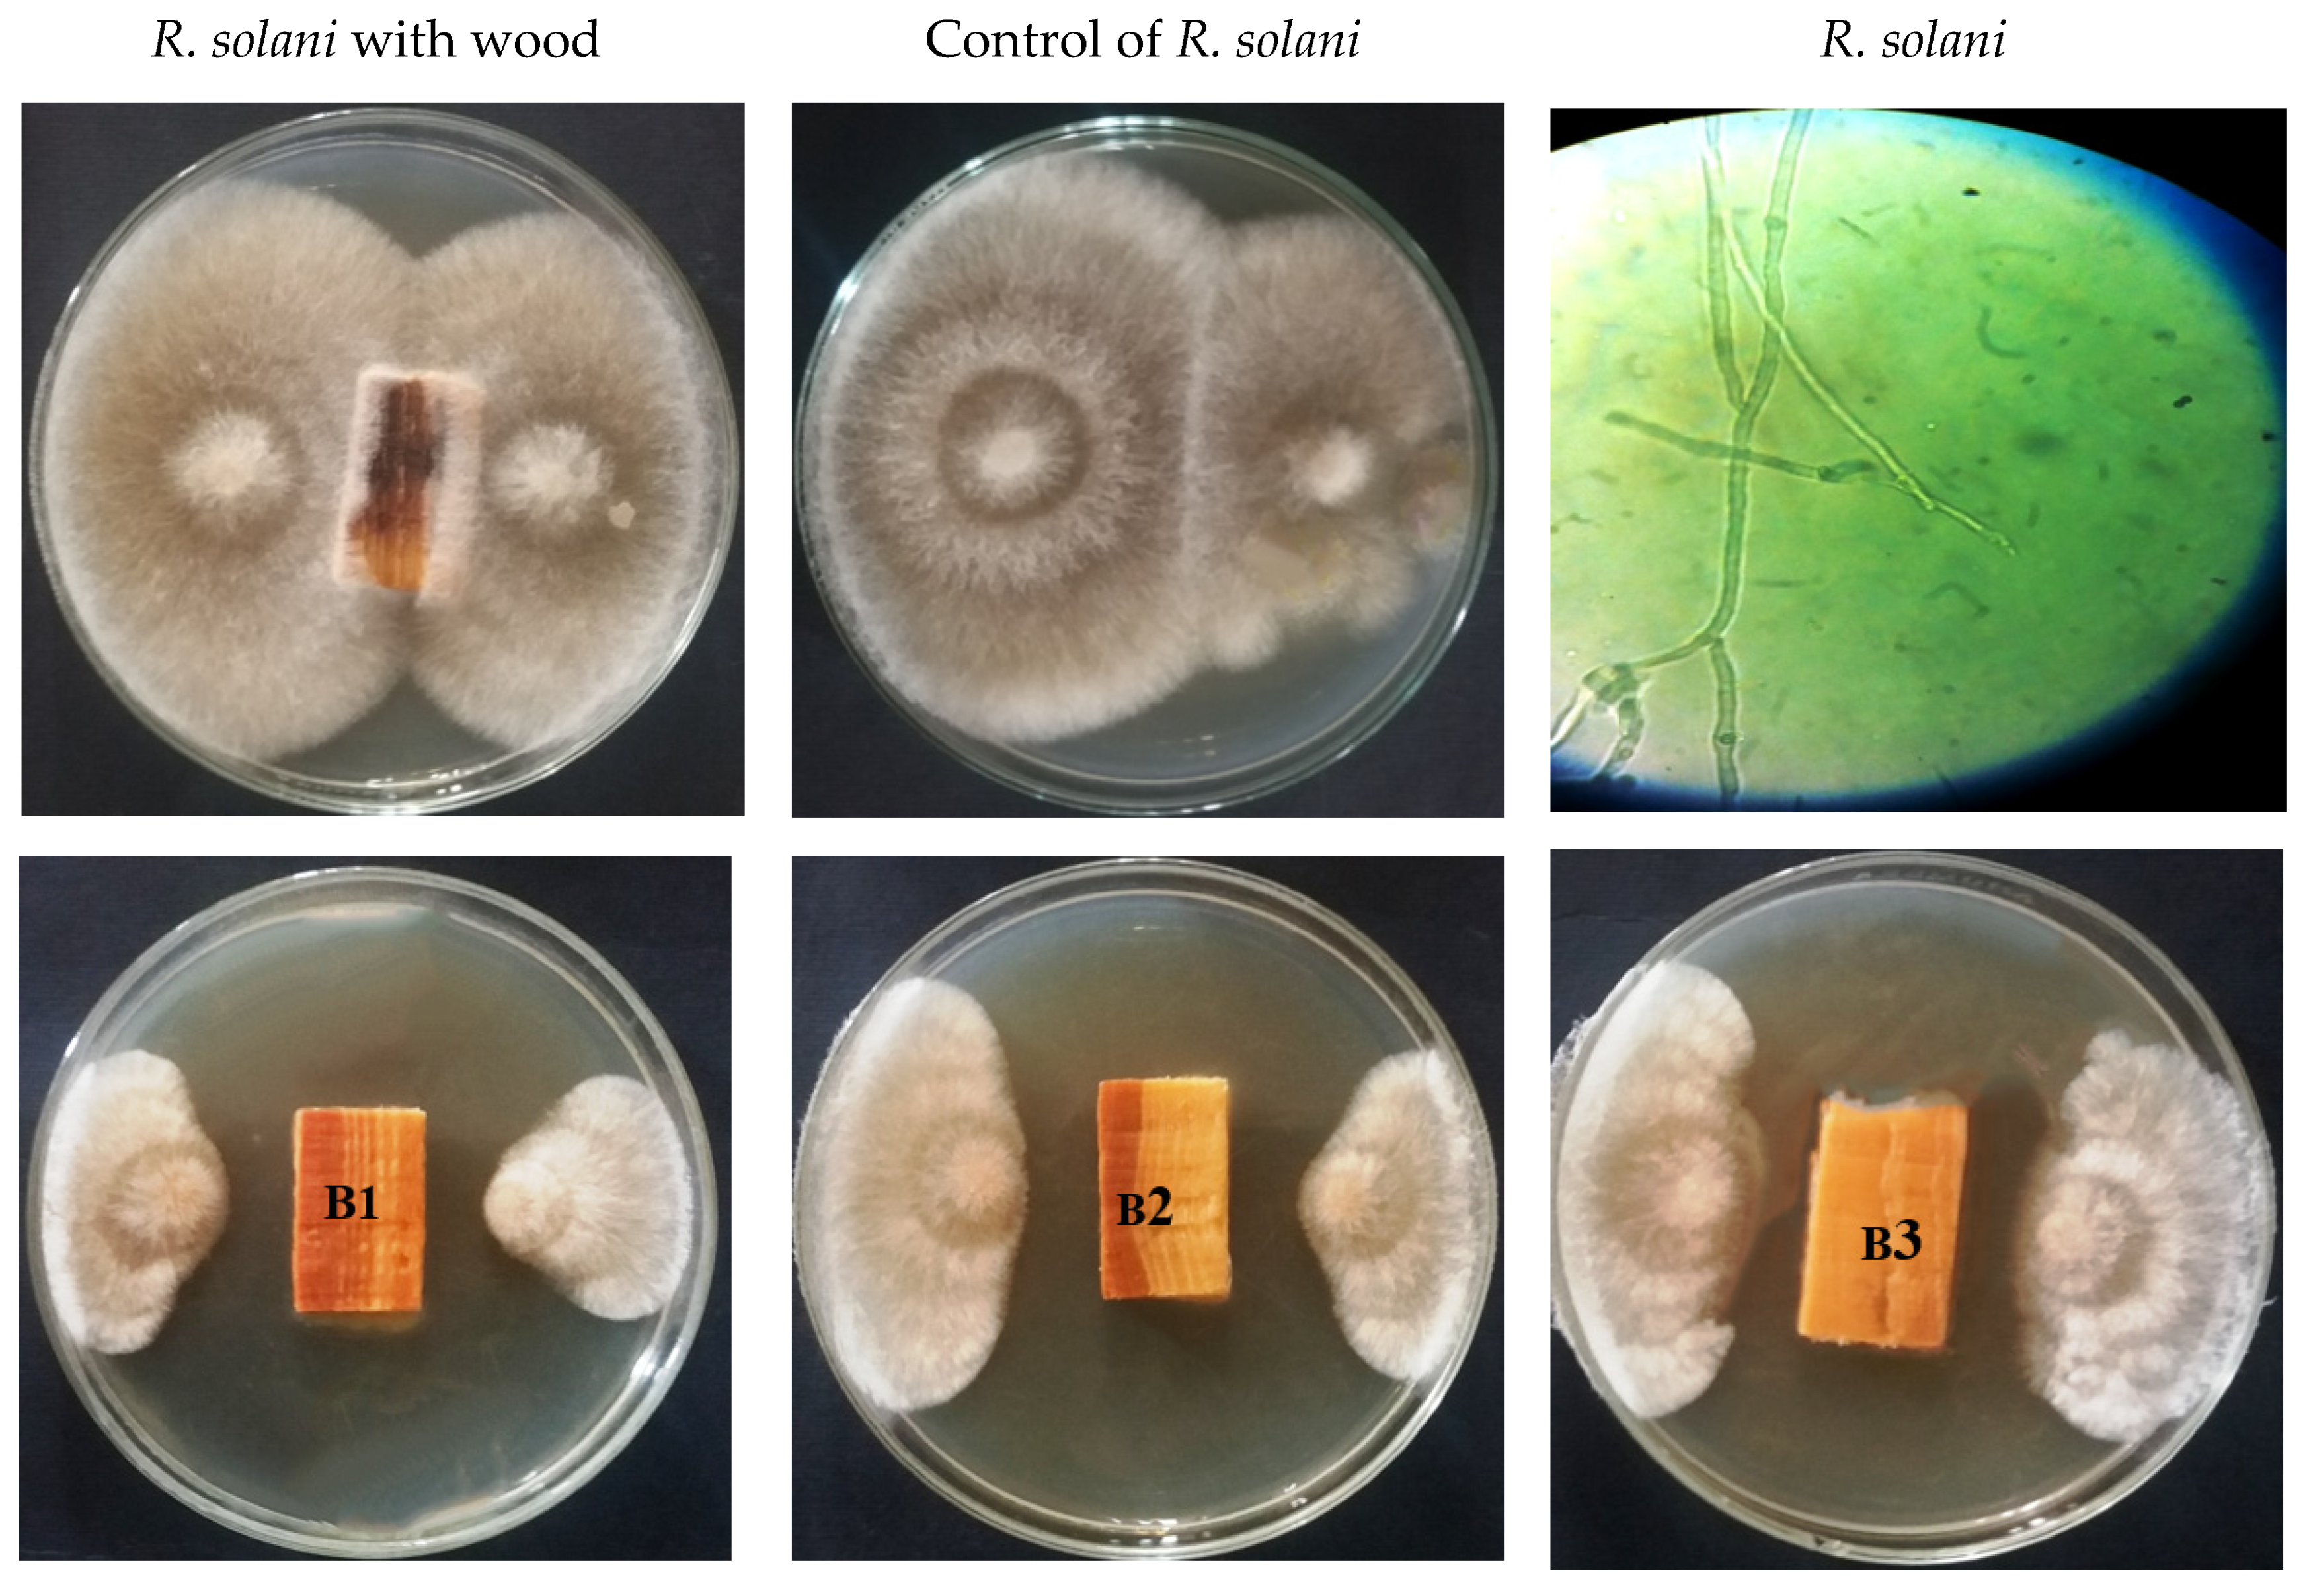
Processes 08 00330 g004a
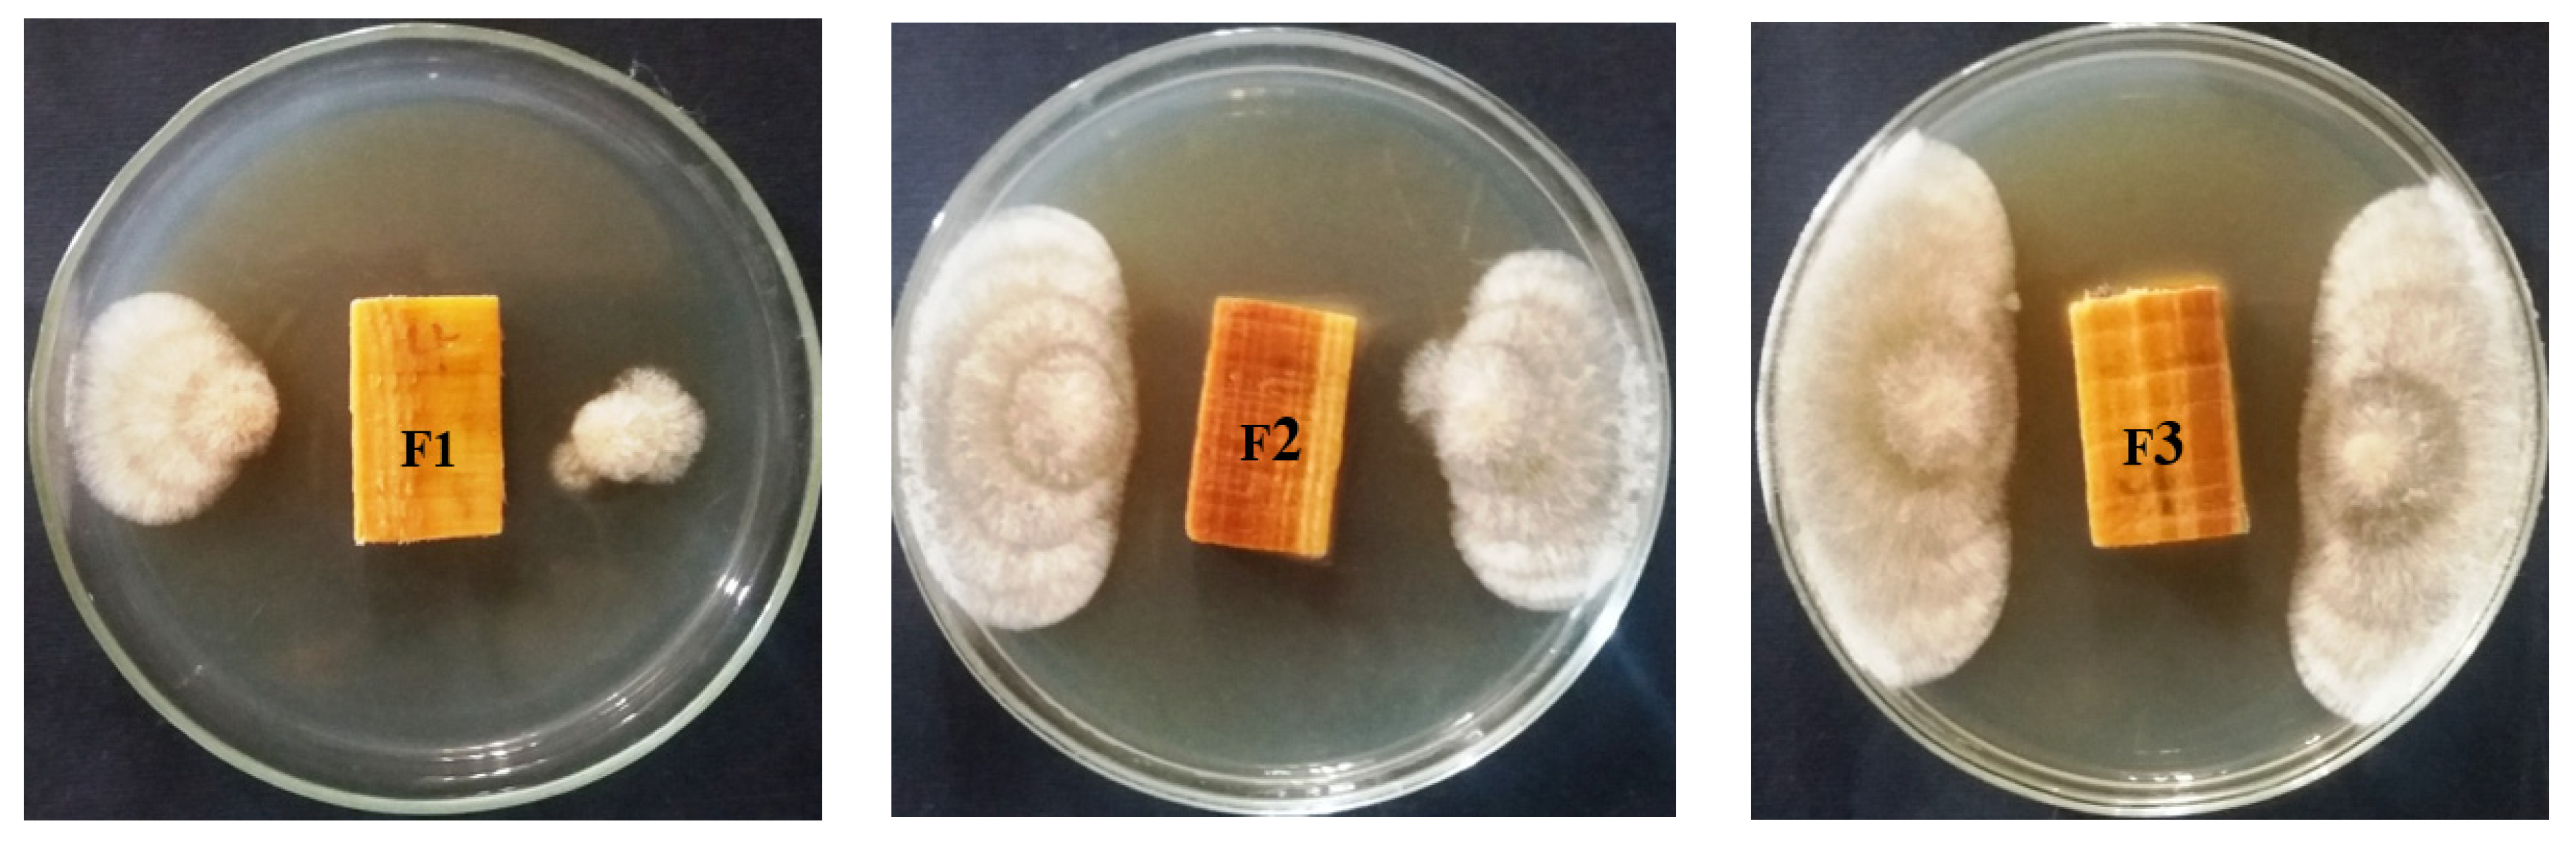
Processes 08 00330 g004b

Phytochemical Compounds of Branches from P. halepensis Oily Liquid Extract and S. terebinthifolius Essential Oil and Their Potential Antifungal Activity
Abstract
1. Introduction
2. Materials and Methods
2.1. Preparation of Essntial Oil and n-Hexane Oily Liquid Extract
2.2. The Antifungal Activity of Wood Treated with Essential Oil and Oily Lquid Extract
2.3. Gas Chromatography-Mass Spectrometry (GC/MS) Analysis of the EO and OLE
2.4. Statistical Analysis
3. Results
3.1. Visual Observations of the Fungal Growth
3.2. Antifungal Activity of the Oils
3.3. Chemical Composition of Branches from S. terebinthifolius Eessntial Oil and P. halepensis Oily Liquid Extract
4. Discussion
5. Conclusions
Author Contributions
Funding
Acknowledgments
Conflicts of Interest
References
- Mansour, M.M.A.; EL-Hefny, M.; Salem, M.Z.M.; Ali, H.M. The Biofungicide Activity of Some Plant Essential Oils for the Cleaner Production of Model Linen Fibers Similar to Those Used in Ancient Egyptian Mummification. Processes 2020, 8, 79. [Google Scholar] [CrossRef]
- Salem, M.Z.M.; Hamed, S.A.M.; Mansour, M.M.A. Assessment of efficacy and effectiveness of some extracted bio-chemicals as bio-fungicides on Wood. Drv. Ind. 2019, 70, 337–350. [Google Scholar] [CrossRef]
- Salem, M.Z.M.; Behiry, S.I.; EL-Hefny, M. Inhibition of Fusarium culmorum, Penicillium chrysogenum and Rhizoctonia solani by n-hexane extracts of three plant species as a wood-treated oil fungicide. J. Appl. Microbiol. 2019, 126, 1683–1699. [Google Scholar] [CrossRef]
- Salem, M.Z.M.; Mansour, M.M.A.; Elansary, H.O. Evaluation of the effect of inner and outer bark extracts of Sugar Maple (Acer saccharum var. saccharum) in combination with citric acid against the growth of three common molds. J. Wood Chem. Technol. 2019, 39, 136–147. [Google Scholar] [CrossRef]
- Mohamed, W.A.; Mansour, M.M.A.; Salem, M.Z.M. Lemna gibba and Eichhornia crassipes extracts: Clean alternatives for deacidification, antioxidation and fungicidal treatment of historical paper. J. Clean. Prod. 2019, 219, 846–855. [Google Scholar] [CrossRef]
- EL-Hefny, M.; Abo Elgat, W.A.A.; Al-Huqail, A.A.; Ali, H.M. Essential and recovery oils from Matricaria chamomilla flowers as environmentally friendly fungicides against four fungi isolated from cultural heritage objects. Processes 2019, 7, 809. [Google Scholar] [CrossRef]
- Behiry, S.I.; Okla, M.K.; Alamri, S.A.; EL-Hefny, M.; Salem, M.Z.M.; Alaraidh, I.A.; Ali, H.M.; Al-Ghtani, S.M.; Monroy, J.C.; Salem, A.Z.M. Antifungal and antibacterial activities of Musa paradisiaca L. peel extract: HPLC analysis of phenolic and flavonoid contents. Processes 2019, 7, 215. [Google Scholar] [CrossRef]
- Al-Huqail, A.A.; Behiry, S.I.; Salem, M.Z.M.; Ali, H.M.; Siddiqui, M.H.; Salem, A.Z.M. Antifungal, antibacterial, and antioxidant activities of Acacia saligna (Labill.) H. L. Wendl. flower extract: HPLC analysis of phenolic and flavonoid compounds. Molecules 2019, 24, 700. [Google Scholar] [CrossRef] [PubMed]
- Ashmawy, N.A.; Al Farraj, D.A.; Salem, M.Z.M.; Elshikh, M.S.; Al-Kufaidy, R.; Alshammari, M.k.; Salem, A.Z.M. Potential impacts of Pinus halepensis Miller trees as a source of phytochemical compounds: Antibacterial activity of the cones essential oil and n-butanol extract. Agrofor. Syst. 2018. [Google Scholar] [CrossRef]
- Shabana, Y.M.; Abdel-Fattah, G.M.; Ismail, A.E.; Rashad, Y.M. Control of brown spot pathogen of rice (Bipolaris oryzae) using some phenolic antioxidants. Braz. J. Microbiol. 2008, 39, 438–444. [Google Scholar] [CrossRef]
- Olivain, C.; Trouvelot, S.; Binet, M.; Cordier, C.; Pugin, A.; Alabouvette, C. Colonization of flax roots and early physiological responses of flax cells inoculated with pathogenic and non-pathogenic strains of Fusarium oxysporum. Appl. Environ. Microb. 2003, 69, 5453–5462. [Google Scholar] [CrossRef] [PubMed]
- Coleman, J.J. The Fusarium solani species complex: Ubiquitous pathogens of agricultural importance. Mol. Plant Pathol. 2016, 17, 146–158. [Google Scholar] [CrossRef] [PubMed]
- Homa, M.; Galgóczy, L.; Manikandan, P.; Narendran, V.; Sinka, R.; Csernetics, Á.; Papp, T. South Indian Isolates of the Fusarium solani Species Complex from Clinical and Environmental Samples: Identification, Antifungal Susceptibilities, and Virulence. Front. Microbiol. 2018, 9. [Google Scholar] [CrossRef] [PubMed]
- Dean, R.; Van Kan, J.A.; Pretorius, Z.A.; Hammond-Kosack, K.E.; Di Pietro, A.; Spanu, P.D.; Rudd, J.J.; Dickman, M.; Kahmann, R.; Ellis, J. The top 10 fungal pathogens in molecular plant pathology. Mol. Plant Pathol. 2012, 13, 414–430. [Google Scholar] [CrossRef]
- Villarino, M.; de la Lastra, E.; Basallote, M.J.; Capote, N.; Inmaculada, L.; Melgarejo, P.; De Cal, A. Characterization of Fusarium solani populations associated with Spanish strawberry crops. Plant Dis. 2019. [Google Scholar] [CrossRef]
- El-Shafey, R.A.S.; Elamawi, R.M.; Saleh, M.M.; Tahoon, A.M.; Emeran, A.A. Morphological, pathological and molecular characterisation of rice sheath blight disease causal organism Rhizoctonia solani AG-1 IA in Egypt. Arch. Phytopathol. Plant Prot. 2019. [Google Scholar] [CrossRef]
- Tumen, I.; Hafizoglu, H.; Kilic, A.; Dönmez, I.E.; Sivrikaya, H.; Reunanen, M. Yields and constituents of essential oil from cones of Pinaceae spp. natively grown in Turkey. Molecules 2010, 15, 5797–5806. [Google Scholar] [CrossRef]
- Abi-Ayad, M.; Abi-Ayad, F.Z.; Lazzouni, H.A.; Rebiahi, S.A.; Ziani-Cherif, C.; Bessiere, J.M. Chemical composition and antifungal activity of Aleppo pine essential oil. J. Med. Plant Res. 2010, 5, 5433–5436. [Google Scholar]
- Abi-Ayad, M.; Abi-Ayad, F.Z.; Lazzouni, H.A.; Rebiahi, S.A. Antibacterial activity of Pinus halepensis essential oil from Algeria (Tlemcen). J. Nat. Prod. Plant Resour. 2010, 1, 33–36. [Google Scholar]
- Nam, A.M.; Tomi, F.; Gibernau, M.N.; Cordier, C.; Pugin, A.; Alabouvette, C. Composition and chemical variability of the needle oil from Pinus halepensis growing in Corsica. Chem. Biodivers. 2016, 13, 380–386. [Google Scholar] [CrossRef]
- Mohareb, A.S.O.; Kherallah, I.E.A.; Badawy, M.E.I.; Salem, M.Z.M.; Hameda, A.Y. Chemical composition and activity of bark and leaf extracts of Pinus halepensis and Olea europaea grown in AL-Jabel AL-Akhdar region, Libya against some plant phytopathogens. J. Appl. Biotechnol. Bioeng. 2017, 3, 331–342. [Google Scholar]
- Dob, T.; Berramdane, T.; Chelghoum, C. Essential oil composition of Pinus halepensis Mill. from three different regions of Algeria. J. Essent. Oil Res. 2007, 19, 40–43. [Google Scholar] [CrossRef]
- Djerrad, Z.; Djouahri, A.; Kadik, L. Variability of Pinus halepensis Mill. Essential oils and their antioxidant activities depending on the stage of growth during vegetative cycle. Chem. Biodivers. 2017, 14, e1600340. [Google Scholar] [CrossRef] [PubMed]
- Nam, A.M.; Casanova, J.; Tomi, F.; Bighelli, A. Composition and chemical variability of Corsican Pinus halepensis cone oil. Nat. Prod. Commun. 2014, 9, 1361–1364. [Google Scholar] [CrossRef]
- Byers, J.A. Chemical Ecology of Insects 2; Chapman and Hall: New York, NY, USA, 1995; pp. 154–213. [Google Scholar]
- Salem, M.Z.M.; EL-Hefny, M.; Ali, H.M.; Elansary, H.O.; Nasser, R.A.; El-Settawy, A.A.A.; El Shanhorey, N.; Ashmawy, N.A.; Salem, A.Z.M. Antibacterial activity of extracted bioactive molecules of Schinus terebinthifolius ripened fruits against some pathogenic bacteria. Microb. Pathogen. 2018, 120, 119–127. [Google Scholar] [CrossRef]
- Lloyd, H.A.; Jaouni, T.M.; Evans, S.L.; Morton, J.F. Terpenes of Schinus terebinthifolius. Phytochemistry 1977, 16, 1301–1302. [Google Scholar] [CrossRef]
- Kassem, M.E.S.; El-Desoky, S.K.; Sharaf, M. Biphenyl esters and bioflavonoids from the fruits of Schinus terebinthifolius. Chem. Nat. Compd. 2004, 40, 447–450. [Google Scholar] [CrossRef]
- Lima, M.R.F.; Luna, J.S.; Santos, A.F.; Andrade, M.C.C.; Sant’ana, A.E.G.; Genet, J.P.; Marquez, B.; Neuville, L.; Moreau, N. Anti-bacterial activity of some Brazilian medicinal plants. J. Ethnopharmacol. 2006, 105, 137–147. [Google Scholar] [CrossRef]
- Ceruks, M.; Romoff, P.; Fávero, O.A.; Lago, J.H.G. Constituintes fenólicos polares de Schinus terebinthifolius Raddi (Anacardiaceae). Quím. Nova 2007, 30, 597–599. [Google Scholar] [CrossRef]
- Degáspari, C.H.; Waszczynskyj, N.; Prado, M.R.M. Atividade antimicrobiana de Schinus terebinthifolius Raddi. Cienc. E Agrotecnol 2005, 29, 617–622. [Google Scholar] [CrossRef]
- Braga, F.G.; Bouzada, M.L.; Fabri, R.L.; Matos, M.O.; Moreira, F.O.; Scio, E.; Coimbra, E.S. Antileishmanial and antifungal activity of plants used in traditional medicine in Brazil. J. Ethnopharmacol. 2007, 111, 396–402. [Google Scholar] [CrossRef]
- Schmourlo, G.; Mendonça-Filho, R.R.; Alviano, C.S.; Costa, S.S. Screening of antifungal agents using ethanol precipitation and bioautography of medicinal and food plants. J. Ethnopharmacol. 2005, 96, 563–568. [Google Scholar] [CrossRef]
- Johann, S.; Sá, N.P.; Lima, L.A.R.S.; Cisalpino, P.S.; Cota, B.B.; Alves, T.M.A.; Siqueira, E.P.; Zani, C.L. Antifungal activity of schinol and a new biphenyl compound isolated from Schinus terebinthifolius against the pathogenic fungus Paracoccidioides brasiliensis. Ann. Clin. Microbiol. Antimicrob. 2010, 9, 30. [Google Scholar] [CrossRef]
- Viitanen, H.; Ritschkoff, A.C. Mold Growth in Pine and Spruce Sapwood in Relation to Air Humidity and Temperature; Report No. 221; Swedish University of Agricultural Sciences, Department of Forest Products: Uppsala, Sweden, 1991. [Google Scholar]
- Ţura, D.; Wasser, S.P.; Zmitrovich, I.V. Wood-Inhabiting Fungi: Applied Aspects. In Fungi: Applications and Management Strategies; Sunil, K., Deshmukh, J.K., Misra, J.P., Tewari, T.P., Eds.; Chapter: 12; CRC Press: Boca Raton, FL, USA, 2016. [Google Scholar]
- Salem, M.Z.M. EDX measurements and SEM examination of surface of some imported woods inoculated by three mold fungi. Measurement 2016, 86, 301–309. [Google Scholar] [CrossRef]
- Mansour, M.M.A.; Salem, M.Z.M.; Khamis, M.H.; Ali, H.M. Natural durability of Citharexylum spinosum and Morus alba woods against three mold fungi. BioResources 2015, 10, 5330–5344. [Google Scholar] [CrossRef][Green Version]
- Mansour, M.M.A.; Abdel-Megeed, A.; Nasser, R.A.; Salem, M.Z.M. Comparative evaluation of some woody trees methanolic extracts and Paraloid B-72 against phytopathogenic mold fungi Alternaria tenuissima and Fusarium culmorum. BioResources 2015, 10, 2570–2584. [Google Scholar] [CrossRef]
- EL-Hefny, M.; Salem, M.Z.M.; Behiry, S.I.; Ali, H.M. The potential antibacterial and antifungal activities of wood treated with Withania somnifera fruit extract, and the phenolic, caffeine and flavonoid composition of the extract according to HPLC. Processes 2020, 8, 113. [Google Scholar] [CrossRef]
- Dayan, F.E.; Cantrell, C.L.; Duke, S.O. Natural products in crop protection. Bioorg. Med. Chem. 2009, 17, 4022–4034. [Google Scholar] [CrossRef] [PubMed]
- Tinkeu, L.; Goudoum, S.N.; Ngassoum, A.; Mapongmetsem, M.B.; Kouninki, P.M.; Hance, T. Persistence of the insecticidal activity of five essential oils on the maize weevil Sitophilus zeamais (Motsch.) (Coleoptera: Curculionidae), Commun. Agric. Appl. Biol. Sci. 2004, 69, 145–147. [Google Scholar]
- Zhu, J.; Zeng, X.; Ma, Y.; Liu, T.; Qian, K.; Han, Y.; Xue, S.; Tucker, B.; Schultz, G.; Coats, J.; et al. Adult repellency and larvicidal activity of five plant essential oils against mosquitoes. J. Am. Mosq. Control Assoc. 2006, 22, 515–522. [Google Scholar] [CrossRef]
- Jaenson, T.G.T.; Garboui, S.; På lsson, K. Repellency of oils of lemon Eucalyptus, Geranium, and Lavender and the mosquito repellent MyggA Natural to Ixodes ricinus (Acari: Ixodidae) in the laboratory and field. J. Med. Entomol. 2006, 43, 731–736. [Google Scholar] [CrossRef] [PubMed]
- US EPA (United States Environment Protection Agency), p-Menthane-3,8-diol (011550) Fact Sheet. 2000. Available online: https://www3.epa.gov/pesticides/chem_search/reg_actions/registration/fs_PC-011550_01-Apr-00.pdf (accessed on 21 February 2020).
- Gardulf, A.; Wohlfart, I.; Gustafson, R. A prospective cross-over field trial shows protection of lemon Eucalyptus extract against tick bites. J. Med. Entomol. 2004, 41, 1064–1067. [Google Scholar] [CrossRef] [PubMed]
- Chou, J.T.; Rossignol, P.A.; Ayres, J.W. Evaluation of commercial insect repellents on human skin against Aedes aegypti (Diptera: Culicidae). J. Med. Entomol. 1997, 34, 624–630. [Google Scholar] [CrossRef] [PubMed]
- Schwan-Estrada, K.R.F.; Stangarlin, J.R.; Cruz, M.E.S. Uso de plantas medicinais no controle de doenças de plantas. Fitopatol. Bras. 2003, 28, 554–556. [Google Scholar]
- Lucas, G.C.; Alves, E.; Pereira, R.B.; Perina, F.J.; de Souza, R.M. Antibacterial activity of essential oils on Xanthomonas vesicatoria and control of bacterial spot in tomato. Pesqui. Agropecuária Bras. 2012, 47, 351–359. [Google Scholar] [CrossRef]
- Halfeld-vieira, B.A.; Romeiro, R.S.; Mizubuti, E.S.G. Isolation methods of tomato phylloplane bacteria aiming specific populations and implications as biocontrol agents. Fitopatol. Bras. 2004, 29, 638–643. [Google Scholar] [CrossRef]
- Okla, M.K.; Alamri, S.A.; Salem, M.Z.M.; Ali, H.M.; Behiry, S.I.; Nasser, R.A.; Alaraidh, I.A.; Al-Ghtani, S.M.; Soufan, W. Yield, phytochemical constituents, and antibacterial activity of essential oils from the leaves/twigs, branches, branch wood, and branch bark of Sour Orange (Citrus aurantium L.). Processes 2019, 7, 363. [Google Scholar] [CrossRef]
- Mansour, M.M.A.; Salem, M.Z.M. Evaluation of wood treated with some natural extracts and Paraloid B-72 against the fungus Trichoderma harzianum: Wood elemental composition, In-vitro and application evidence. Inter. Biodeterior. Biodegrad. 2015, 100, 62–69. [Google Scholar] [CrossRef]
- Salem, M.Z.M.; Mansour, M.M.A.; Mohamed, W.S.; Ali, H.M.; Hatamleh, A.A. Evaluation of the antifungal activity of treated Acacia saligna wood with Paraloid B-72/TiO2 nanocomposites against the growth of Alternaria tenuissima, Trichoderma harzianum, and Fusarium culmorum. BioResources 2017, 12, 7615–7627. [Google Scholar]
- Salem, M.Z.M.; Zidan, Y.E.; Mansour, M.M.A.; El Hadidi, N.M.N.; Abo Elgat, W.A.A. Evaluation of usage three natural extracts applied to three commercial wood species against five common molds. Int. Biodeterior. Biodegrad. 2016, 110, 206–226. [Google Scholar] [CrossRef]
- Salem, M.Z.M.; Zidan, Y.E.; Mansour, M.M.A.; El Hadidi, N.M.N.; Abo Elgat, W.A.A. Antifungal activities of two essential oils used in the treatment of three commercial woods deteriorated by five common mold fungi. Int. Biodeterior. Biodegrad. 2016, 106, 88–96. [Google Scholar] [CrossRef]
- NIST/EPA/NIH Mass. Spectral Library (NIST 14) and NIST Mass Spectral Search Program (Version 2.0g) May 2014. Available online: https://www.sisweb.com/software/ms/nist.htm (accessed on 10 January 2020).
- Abdelsalam, N.R.; Salem, M.Z.M.; Ali, H.M.; Mackled, M.I.; EL-Hefny, M.; Elshikh, M.S.; Hatamleh, A.A. Morphological, biochemical, molecular, and oil toxicity properties of Taxodium trees from different locations. Indu. Crop. Prod. 2019, 139, 111515. [Google Scholar] [CrossRef]
- SAS. User Guide: Statistics (Release 8.02); SAS Institute: Cary, NC, USA, 2001. [Google Scholar]
- Kozan, E.; Küpeli, E.; Yesilada, E. Evaluation of some plants used in turkish folk medicine against parasitic infections for their in vivo anthelmintic activity. J. Ethnopharmacol. 2006, 108, 211–216. [Google Scholar] [CrossRef] [PubMed]
- Senouci, F.; Ababou, A.; Chouieb, M. Ethnobotanical Survey of the Medicinal Plants used in the Southern Mediterranean. Case Study: The Region of Bissa (Northeastern Dahra Mountains, Algeria). Pharmacogn. J. 2019, 11, 647–659. [Google Scholar] [CrossRef]
- Pasqualini, V.; Robles, C.; Garzino, S.; Greff, S.; Bousquet-Mélou, A.; Bonin, G. Phenolic compounds content in Pinus halepensis Mill. Needles: A bioindicator of air pollution. Chemosphere 2003, 52, 239–248. [Google Scholar] [CrossRef]
- Benouadah, N.; Pranovich, A.; Aliouche, D.; Hemming, J.; Smeds, A.; Willför, S. Analysis of extractives from Pinus halepensis and Eucalyptus camaldulensis as predominant trees in Algeria. Holzforschung 2017, 72, 97–104. [Google Scholar] [CrossRef]
- Benouadah, N.; Aliouche, D.; Pranovich, A.; Willför, S. Chemical characterization of Pinus halepensis sapwood and heartwood. Wood Mater. Sci. Eng. 2019, 14, 157–164. [Google Scholar] [CrossRef]
- Cheikh-Rouhou, S.; Hentati, B.; Besbes, S.; Blecker, C.; Deroanne, C.; Attia, H. Chemical Composition and Lipid Fraction Characteristics of Aleppo Pine (Pinus halepensis Mill.) Seeds Cultivated in Tunisia. Food Sci. Technol. Int. 2006, 12, 407–415. [Google Scholar] [CrossRef]
- El-Shazli, E.M.; Hafezh, S.S.; Abdel-Ghany, A.E. Analysis of the essential oils of S. terebinthifolius Raddi cultivated in Egypt. Zagazig J. Pharm. Sci. 2000, 9, 1–8. [Google Scholar]
- Chowdhury, A.R.; Tripathi, S. Essential oil from leaves of S. terebinthifolius Raddi. Indian Perfum. 2001, 4, 257–259. [Google Scholar]
- Barbosa, L.C.A.; Demuner, A.J.; Clemente, A.D.; De Paula, V.F.; Ismail, F.M.D. Seasonal variation in the composition of volatile oils from Schinus terebinthifolius Raddi. Quim. Nova 2007, 30, 1959–1965. [Google Scholar] [CrossRef]
- Bendaoud, H.; Romdhane, M.; Souchard, J.P.; Cazaux, S.; Bouajila, J. Chemical composition and anticancer and antioxidant activities of Schinus Molle L. and Schinus terebinthifolius Raddi berries essential oils. J. Food Sci. 2010, 75, 466–472. [Google Scholar] [CrossRef]
- Richter, R.; Von Reuß, S.H.; König, W.A. Spirocyclopropane-type sesquiterpene hydrocarbons from Schinus terebinthifolius Raddi. Phytochemistry 2010, 71, 1371–1374. [Google Scholar] [CrossRef]
- Cole, E.R.; dos Santos, R.B.; Lacerda Júnior, V.; Martins, J.D.L.; Greco, S.J.; Cunha Neto, A. Chemical composition of essential oil from ripe fruit of Schinus terebinthifolius Raddi and evaluation of its activity against wild strains of hospital origin. Braz. J. Microbiol. 2014, 45, 821–828. [Google Scholar] [CrossRef]
- Hussein, H.S.; Salem, M.Z.M.; Soliman, A.M. Repellent, attractive, and insecticidal effects of essential oils from Schinus terebinthifolius fruits and Corymbia citriodora leaves on two whitefly species, Bemisia tabaci and Trialeurodes ricini. Sci. Hortic. 2017, 216, 111–119. [Google Scholar] [CrossRef]
- Périno-Issartier, S.; Abert-Vian, M.; Petitcolas, E.; Chemat, F. Microwave turbo hydrodistillation for rapid extraction of the essential oil from Schinus terebinthifolius Raddi berries. Chromatographia 2010, 72, 347–350. [Google Scholar] [CrossRef]
- Carvalho, M.G.; Melo, A.G.N.; Aragão, C.F.S.; Raffin, F.N.; Moura, T.F.A.L. Schinus terebinthifolius Raddi: Chemical composition, biological properties and toxicity. Rev. Bras. Plantas Med. (Botucatu) 2013, 15, 158–169. [Google Scholar] [CrossRef]
- Santana, J.S.; Sartorelli, P.; Guadagnin, R.C.; Matsuo, A.L.; Figueiredo, C.R.; Soares, M.G.; Da Silva, A.M.; Lago, J.H.G. Essential oils from Schinus terebinthifolius leaves—Chemical composition and in vitro cytotoxicity evaluation. Pharm. Biol. 2012, 50, 1248–1253. [Google Scholar] [CrossRef] [PubMed]
- Mohamed, A.A.; Behiry, S.I.; Younes, H.A.; Ashmawy, N.A.; Salem, M.Z.M.; Márquez-Molina, O.; Barbabosa, O.A. Antibacterial activity of three essential oils and five monoterpenes against Ralstonia solanacearum phylotype II isolated from potato. Microb. Pathogen. 2019, 135, 103604. [Google Scholar] [CrossRef] [PubMed]
- Dannenberg, G.S.; Funck, G.D.; Silva, W.P.; Fiorentini, Â.M. Essential oil from pink pepper (Schinus terebinthifolius Raddi): Chemical composition, antibacterial activity and mechanism of action. Food Control 2019, 95, 115–120. [Google Scholar] [CrossRef]
- Santos, A.C.A.; Rossato, M.; Serafini, L.A.; Bueno, M.; Crippa, L.B.; Sartori, V.C.; Dellacassa, E.; Moyna, P. Efeito fungicida dos óleos essenciais de Schinus molle L. e Schinus terebinthifolius Raddi, Anacardiaceae, do Rio Grande do Sul. Rev. Bras. Farmacogn. 2010, 20, 154–159. [Google Scholar] [CrossRef]
- Filipowicz, N.; Kamiński, M.; Kurlenda, J.; Asztemborska, M. Antibacterial and antifungal activity of Juniper Berry oil and its selected components. Phytother. Res. 2003, 17, 227–231. [Google Scholar] [CrossRef] [PubMed]
- Helander, I.M.; Alakomi, H.L.; KyostiL, K.; Mattiala-andholm, T.; Pol, I.; Smid, E.J.; Gorris, G.M.; von Wright, A. Characterization of the action of selected essential oil components on Graham-negative bacteria. J. Agric. Food. Chem. 1998, 46, 3590–3595. [Google Scholar] [CrossRef]
- Cox, S.D.; Mann, C.M.; Markham, J.L.; Bell, H.C.; Gustafson, J.E.; Warmington, J.R.; Wyllie, S.G. The mode of antimicrobial action of the essential oil of Melaleuca alternifolia (Tea tree oil). J. Appl. Microbiol. 2000, 88, 170–175. [Google Scholar] [CrossRef]
- Recio, M.C.; Rios, J.L. A review of some antimicrobial compounds isolated from medicinal plants reported in the literature 1978–1988. Phytother. Res. 1989, 3, 117–125. [Google Scholar]
- Karaman, S.; Digrak, M.; Ravid, U.; Ilcim, A. Antibacterial and antifungal activity of the essential oils of Thymus revoltus celak from turkey. J. Ethnopharmacol. 2001, 76, 183–186. [Google Scholar] [CrossRef]
- Nedorostova, L.; Kloucek, P.; Kokoska, L.; Stolcova, M.; Pulkraibek, J. Antimicrobial properties of selected essential oils in vapour phase against foodborne bacteria. Food Control 2009, 20, 157–160. [Google Scholar] [CrossRef]
- Harborne, J.B. Plant Phenolics; Academic Press: London, UK, 1989; pp. 23–53. [Google Scholar]
- Conner, D.E. Naturally occurring compounds. In Antimicrobials in Food, 2nd ed.; Davidson, P.M., Branen, A.L., Eds.; Marcel Dekker, Inc.: New York, NY, USA, 1993; pp. 441–467. [Google Scholar]
- Ramos-Nino, M.E.; Ramirez-Rodriguez, C.A.; Clifford, M.N.; Adams, M.R. QSARs for the effect of benzaldehydes on foodborne bacteria and the role of sulphydryl groups as targets of their antibacterial activity. J. Appl. Microbiol. 1998, 84, 207–212. [Google Scholar] [CrossRef]
- Walsh, S.E.; Maillard, J.Y.; Simons, C.; Russell, A.D. Studies on the mechanisms of the antibacterial action of ortho-phthalaldehyde. J. Appl. Bacteriol. 1999, 87, 702–710. [Google Scholar] [CrossRef]
- Bisignano, G.; LaganÃ, M.G.; Trombetta, D.; Arena, S.; Nostro, A.; Uccella, N.; Saija, A. In vitro antibacterial activity of some aliphatic aldehydes from Olea europaea L. FEMS Microbiol. Lett. 2001, 198, 9–13. [Google Scholar] [CrossRef]
- Herruzo-Cabrera, R.; Uriarte, M.C.; Rey-Calero, J. Antimicrobial effectiveness of 2% glutaraldehyde versus other disinfectants for hospital equipment, an in vitro test based on germ carriers with a high microbial contamination. Rev. Stomatol. Chir. Maxillofac. 1999, 6, 299–305. [Google Scholar]
- Taha, A.S.; Salem, M.Z.M.; Abo Elgat, W.A.A.; Ali, H.M.; Hatamleh, A.A.; Abdel-Salam, E.M. Assessment of the impact of different treatments on technological and antifungal properties of produced Papyrus (Cyperus papyrus L.) sheets. Materials 2019, 12, 620. [Google Scholar] [CrossRef]
- Omidbeygi, M.; Barzegar, M.; Hamidi, Z.; Naghdibadi, H. Antifungal activity of thyme, summer savory and clove essential oils against Aspergillus flavus in liquid medium and tomato paste. Food Control 2007, 18, 1518–1523. [Google Scholar] [CrossRef]
- Amri, I.; Gargouri, S.; Hamrouni, L.; Hanana, M.; Fezzani, T.; Jamoussi, B. Chemical composition, phytotoxic and antifungal activities of Pinus pinea essential oil. J. Pest Sci. 2012, 85, 199–207. [Google Scholar] [CrossRef]
- Lucini, E.I.; Zunino, M.P.; Lopez, M.L.; Zygadlo, J.A. Effect of monoterpenes on lipid composition and sclerotial development of Sclerotium cepivorum Berk. J. Phytopathol. 2006, 154, 441–446. [Google Scholar] [CrossRef]
- Cristani, M.; Arrigo, M.; Mandalari, G.; Castelli, F.; Sarpietro, M.G.; Micieli, D.; Venuti, V.; Bisignano, G.; Saija, A.; Trombetta, D. Interaction of four monoterpenes contained in essential oils with model membranes: Implications for their antibacterial activity. J. Agric. Food Chem. 2007, 55, 6300–6308. [Google Scholar] [CrossRef]
- Viuda-Martos, M.; Ruiz-Navajas, Y.; Fernandez-Lopez, J.; Perez-Alvarez, J. Antifungal activity of lemon (Citrus lemon L.), mandarin (Citrus reticulata L.), grapefruit (Citrus paradisi L.) and orange (Citrus sinensis L.) essential oils. Food Control 2008, 19, 1130–1138. [Google Scholar] [CrossRef]
- Tatsadjieu, N.L.; Jazet, D.P.M.; Ngassoum, M.B.; Etoa, F.X.; Mbofung, C.M.F. Investigations on the essential oil of Lippia rugosa from Cameroon for its potential use as antifungal agent against Aspergillus flavus Link ex Fries. Food Control 2009, 20, 161–166. [Google Scholar] [CrossRef]
- Daferera, D.J.; Ziogas, B.N.; Polissiou, M.G. GC–MS analysis of essential oils from some Greek aromatic plants and their fungitoxicity on Penicillium digitatum. J. Agric. Food Chem. 2000, 48, 2576–2581. [Google Scholar] [CrossRef]

| Oil/Extract Type | Concentration (%) | Fungal Inhibition (%) | |||
|---|---|---|---|---|---|
| B. oryzae | F. oxysporum | F. solani | R. solani | ||
| P. halepensis OLE | 0 (control) | 0.00 | 0.00 | 0.00 | 0.00 |
| 1 | 50.55 ± 4.92 | 31.11 ± 4.05 | 20 ± 9.07 | 24.44 ± 4.05 | |
| 2 | 70 ± 5.28 | 35.55 ± 6.60 | 29.44 ± 4.20 | 30.55 ± 7.34 | |
| 3 | 80 ± 1.81 | 40.55 ± 4.58 | 30.55 ± 2.12 | 41.11 ± 2.86 | |
| S. terebinthifolius EO | 0 (control) | 0.00 | 0.00 | 0.00 | 0.00 |
| 1 | 61.11 ± 2.86 | 23.44 ± 2.93 | 13.88 ± 2.12 | 28.33 ± 3.79 | |
| 2 | 71.66 ± 3.79 | 33.33 ± 1.81 | 21.11 ± 2.86 | 35 ± 2.12 | |
| 3 | 74.44 ± 2.86 | 45.55 ± 2.86 | 23.88 ± 2.12 | 54.44 ± 6.91 | |
| p-value | ** | ** | ** | ** | |
| Compound | Chemical Classification | Percentage in the Oil (%) | SI 1 | RSI 2 |
|---|---|---|---|---|
| α-Thujene | Monoterpene | 0.94 | 935 | 954 |
| α-Pinene | Monoterpene | 1.21 | 960 | 962 |
| Sabinene | Monoterpene | 9.83 | 961 | 968 |
| β-Pinene | Monoterpene | 0.32 | 942 | 952 |
| Myrcene | Monoterpene | 1.88 | 943 | 945 |
| α-Terpinene | Monoterpene | 8.56 | 939 | 944 |
| D-Limonene | Monoterpene | 2.79 | 926 | 929 |
| α-Phellandrene | Monoterpene | 2.46 | 918 | 921 |
| o-Cymene | Monoterpene | 4.05 | 926 | 937 |
| γ-Terpinene | Monoterpene | 12.46 | 936 | 941 |
| Artemisia ketone | Monoterpene | 0.33 | 774 | 974 |
| 4-Thujanol | Monoterpene | 6.71 | 888 | 890 |
| Linalool | Monoterpene | 0.74 | 922 | 934 |
| cis-β-Terpineol | Monoterpene | 15.60 | 928 | 937 |
| para-Menth-3-en-1-ol | Monoterpene | 1.85 | 888 | 893 |
| cis-para-2-menthen-1-ol | Monoterpene | 0.64 | 903 | 918 |
| Camphor | Monoterpene | 0.23 | 765 | 820 |
| Terpinen-4-ol | Monoterpene | 18.25 | 931 | 937 |
| (Z)-Piperitol | Monoterpene | 0.28 | 873 | 927 |
| (-)-α-Terpineol | Monoterpene | 4.34 | 941 | 945 |
| trans-Piperitol | Monoterpene | 0.14 | 866 | 925 |
| Linalyl acetate | Monoterpene | 1.63 | 899 | 921 |
| 2,2-Dimethyl-3-vinyl-bicyclo[2.2.1]heptane | Hydrocarbons | 0.26 | 748 | 807 |
| Thymol | Monoterpene | 1.19 | 866 | 903 |
| β-Caryophyllene | Sesquiterpene | 2.34 | 922 | 941 |
| γ-Elemene | Sesquiterpene | 0.95 | 849 | 885 |
| Compound | Chemical Classification | Percentage in the Extract (%) | SI 1 | RSI 2 |
|---|---|---|---|---|
| 2,7-dimethyl-1-Octanol | Terpene hydrocarbon | 0.70 | 706 | 783 |
| 2,6-Dimethyloctane-1,8-diol | Terpene hydrocarbon | 0.25 | 675 | 675 |
| (E)-2-Decen-1-ol | Unsaturated aldehydes | 0.57 | 705 | 775 |
| (2-Hexylcyclopropyl)acetic acid | Hydrocarbons | 0.29 | 718 | 758 |
| 1-Dodecene | Unsaturated aldehydes | 0.47 | 742 | 742 |
| n-Caprylaldehyde | Alkyl aldehyde | 1.31 | 803 | 934 |
| Isopinocarveol | Pinane monoterpene | 0.97 | 708 | 748 |
| (E)-9-Tetradecen-1-ol acetate | Unsaturated aldehydes | 0.45 | 751 | 783 |
| trans-2-Decenal | Unsaturated aldehydes | 0.40 | 884 | 921 |
| (Z)-2-Decenal | Unsaturated aldehydes | 6.88 | 901 | 932 |
| (2E)-2-Decenal | Unsaturated aldehydes | 4.65 | 884 | 919 |
| Nonanal | Fatty aldehydes | 5.85 | 870 | 887 |
| Oxacyclotetradecan-2-one | Ketone | 0.32 | 751 | 752 |
| Methyl octadeca-13,16-diynoate | Fatty acid methyl ester | 2.21 | 742 | 750 |
| 1-Tetradecanol | Saturated fatty alcohol | 0.32 | 767 | 768 |
| (Z)-2-Tridecenal | Unsaturated aldehydes | 2.9 | 771 | 814 |
| Undecanoic acid, hydroxy-, lactone | Fatty acid | 0.19 | 740 | 757 |
| 1,2-15,16-Diepoxyhexadecane | Alkane hydrocarbon | 0.74 | 780 | 782 |
| 5-heptyldihydro-2(3H)-furanone | gamma butyrolactones | 0.32 | 734 | 745 |
| (E,E)-2,4-Decadienal | Unsaturated aldehydes | 4.41 | 838 | 870 |
| (Z)-Oleic acid | Fatty acid | 1.48 | 770 | 770 |
| 2-Undecenal | Unsaturated aldehydes | 22.25 | 890 | 903 |
| Olealdehyde | Aldehydes | 0.69 | 727 | 792 |
| Arachidonic acid methyl ester | Fatty acid methyl ester | 4.36 | 753 | 760 |
| Myristyl chloride | Fatty acid | 1.97 | 735 | 755 |
| Z,Z,Z-1,4,6,9-Nonadecatetraene | Unsaturated aldehydes | 0.68 | 741 | 741 |
| 4-Hydroxy-10-methyl-3,4,7,8,9,10-hexahydro-2H-oxecin-2-one | Ketone | 8.43 | 844 | 890 |
| 2-methylene-(3β,5α)-Cholestan-3-ol | Steroids | 0.87 | 772 | 782 |
| (Z)-7-Hexadecenal | Unsaturated aldehydes | 0.46 | 747 | 890 |
| Vitamin A aldehyde (Retinal) | Retinoids | 0.21 | 701 | 771 |
| 9-Hexadecenoic acid | Fatty acid | 1.08 | 788 | 789 |
| 1-Heptatriacotanol | Fatty alcohol | 1.15 | 728 | 730 |
| O-Benzylserine | Amino acid | 2.22 | 766 | 776 |
| 12,15-Octadecadiynoic acid, methyl ester | Fatty acid | 3.1 | 743 | 753 |
| 2-(7-heptadecynyloxy)tetrahydro-2H-Pyran | Hydrocarbons | 4.22 | 697 | 697 |
| 1-Nonadecene | Hydrocarbons | 3.50 | 724 | 757 |
| Z-(13,14-Epoxy)tetradec-11-en-1-ol acetate | Hydrocarbons | 3.04 | 785 | 794 |
| 7-Methyl-Z-tetradecen-1-ol acetate | Hydrocarbons | 3.01 | 747 | 762 |
© 2020 by the authors. Licensee MDPI, Basel, Switzerland. This article is an open access article distributed under the terms and conditions of the Creative Commons Attribution (CC BY) license (http://creativecommons.org/licenses/by/4.0/).
Share and Cite
Mohamed, A.A.; Behiry, S.I.; Ali, H.M.; EL-Hefny, M.; Salem, M.Z.M.; Ashmawy, N.A. Phytochemical Compounds of Branches from P. halepensis Oily Liquid Extract and S. terebinthifolius Essential Oil and Their Potential Antifungal Activity. Processes 2020, 8, 330. https://doi.org/10.3390/pr8030330
Mohamed AA, Behiry SI, Ali HM, EL-Hefny M, Salem MZM, Ashmawy NA. Phytochemical Compounds of Branches from P. halepensis Oily Liquid Extract and S. terebinthifolius Essential Oil and Their Potential Antifungal Activity. Processes. 2020; 8(3):330. https://doi.org/10.3390/pr8030330
Chicago/Turabian StyleMohamed, Abeer A., Said I. Behiry, Hayssam M. Ali, Mervat EL-Hefny, Mohamed Z.M. Salem, and Nader A. Ashmawy. 2020. "Phytochemical Compounds of Branches from P. halepensis Oily Liquid Extract and S. terebinthifolius Essential Oil and Their Potential Antifungal Activity" Processes 8, no. 3: 330. https://doi.org/10.3390/pr8030330
APA StyleMohamed, A. A., Behiry, S. I., Ali, H. M., EL-Hefny, M., Salem, M. Z. M., & Ashmawy, N. A. (2020). Phytochemical Compounds of Branches from P. halepensis Oily Liquid Extract and S. terebinthifolius Essential Oil and Their Potential Antifungal Activity. Processes, 8(3), 330. https://doi.org/10.3390/pr8030330

